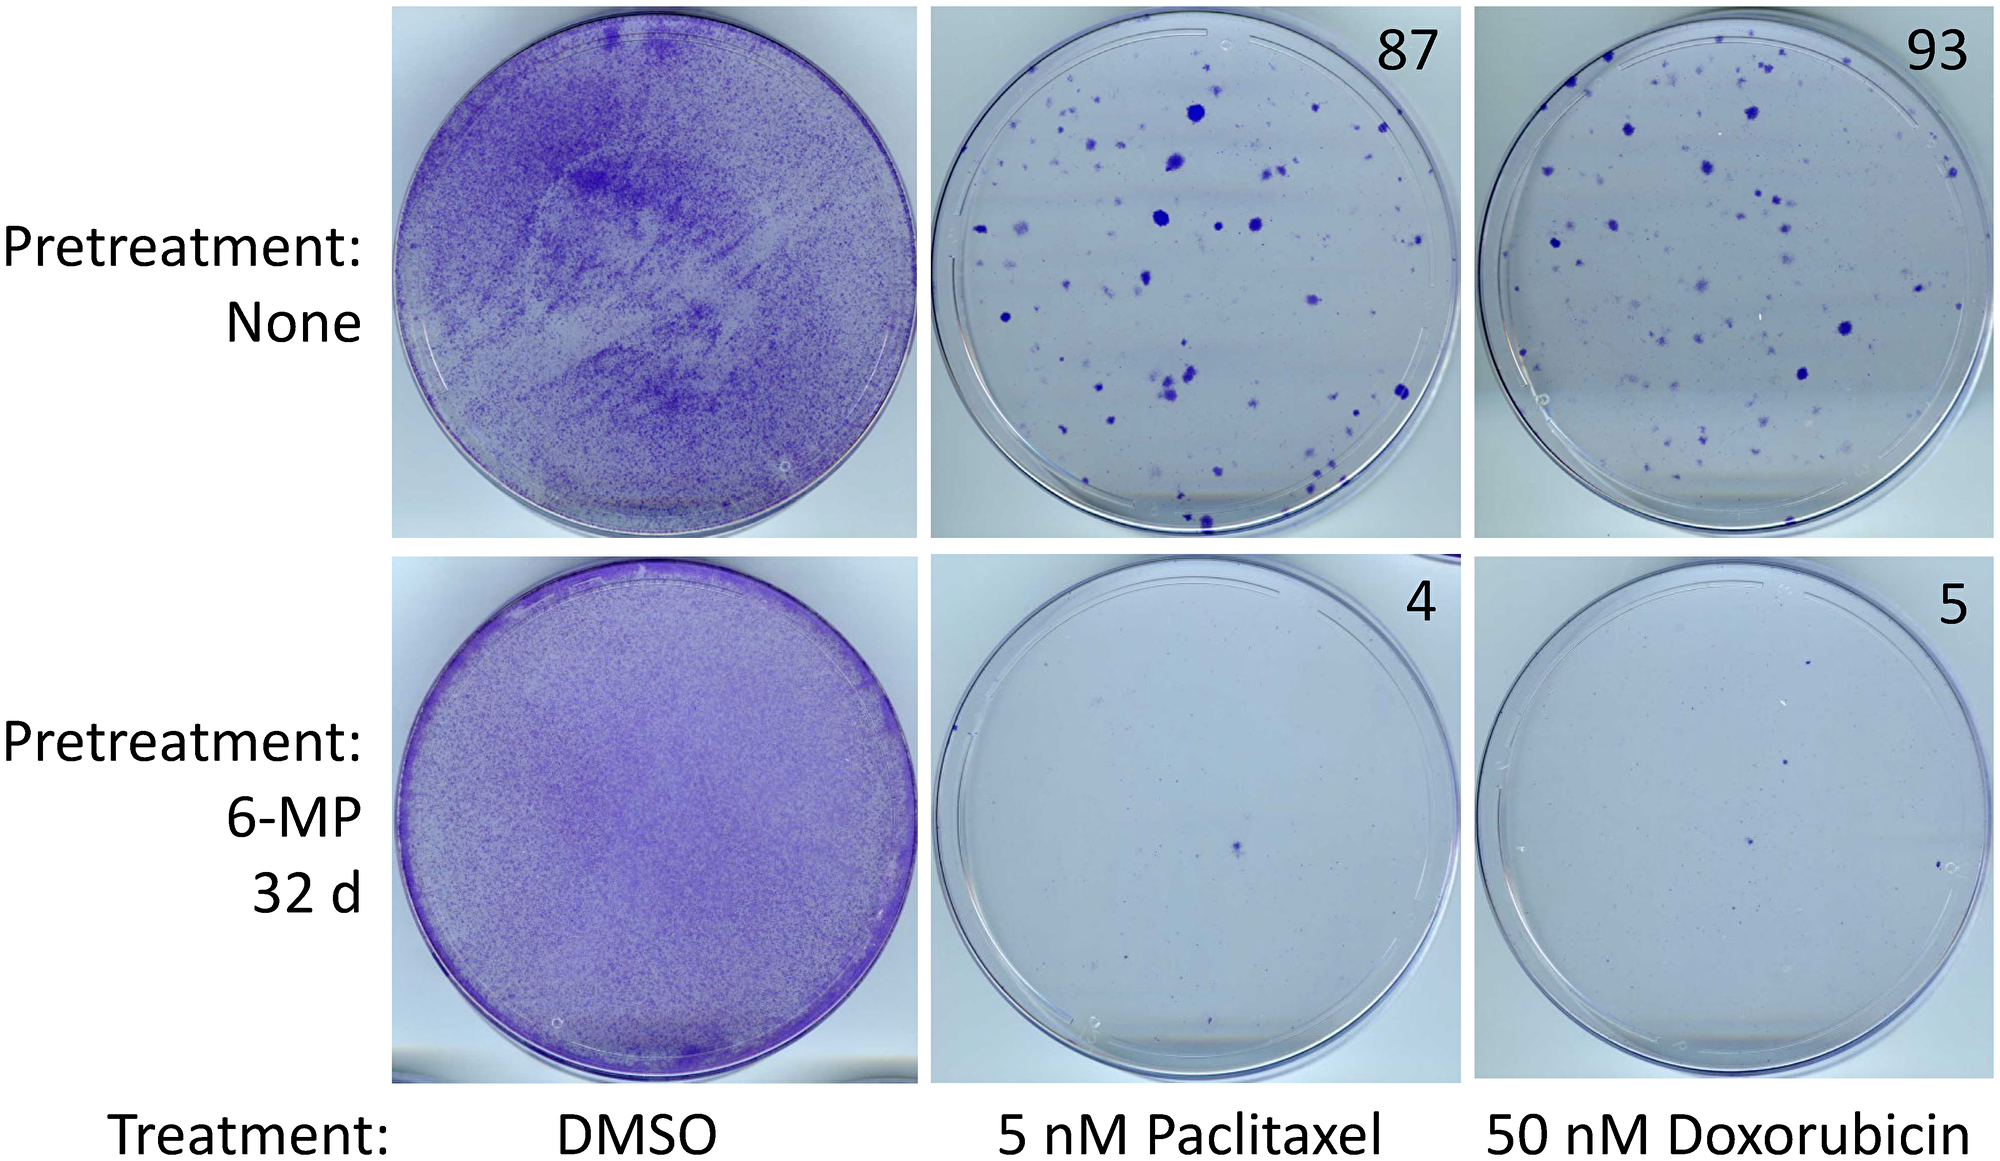
Figure 5: SUM149-MA cells surviving a 6-MP treatment are sensitive to chemotherapeutic drugs.

The cover for issue 7 of Oncotarget features Figure 5, "SUM149-MA cells surviving a 6-MP treatment are sensitive to chemotherapeutic drugs," published in "Inhibition of resistant triple-negative breast cancer cells with low-dose 6-mercaptopurine and 5-azacitidine" by Singh, et al. which reported that the authors have reported that a lengthy treatment with low-dose 6-mercaptopurine, a clinically useful anti-inflammatory drug, inhibits such resistant cells.
They found that a lengthy treatment with 1 μM 5-azacitidine, without a significant effect on cell proliferation, sensitized cancer cells to the inhibitory effects of low-dose 6-mercaptopurine.
Importantly, treatment for several weeks with low doses of 6-mercaptopurine and/or 5-azacitidine did not render cancer cells resistant to chemotherapeutic drugs doxorubicin or paclitaxel.
In fact, the cells became more sensitive to chemotherapeutic drugs upon treatment with 6-mercaptopurine and/or 5-azacitidine.
The Oncotarget author's analyses of protein markers of epithelial-to-mesenchymal transition indicated that treatments with 6-mercaptopurine and/or 5-azacitidine do not significantly reverse this process in their model. Their results showed that safe drugs such as low-dose 6-mercaptopurine singly or combined with 5-azacitidine, which are suitable for use prior to disease relapse, have a potential of inhibiting highly resistant triple-negative breast cancer cells.
The Oncotarget author's analyses of protein markers of epithelial-to-mesenchymal transition indicated that treatments with 6-mercaptopurine and/or 5-azacitidine do not significantly reverse this process in their model.
Dr. Anthony Lucci and Dr. Balraj Singh both from The University of Texas MD Anderson Cancer Center said, "Breast cancer patients who have minimal residual disease (MRD) after surgery or systemic therapies are at a higher risk of relapse."
The model involves choosing cancer cell lines established from therapy-resistant breast cancers, such as inflammatory breast cancer, and subjecting them to prolonged glutamine deficiency to select progenitor-like cancer cells that are highly resistant and can metastasize to multiple organs in nude mice.
To explain this experimental strategy for therapeutic evaluation against resistant cancer cells, although their selection protocol for resistant cells is very robust, a majority of the progeny cells would gradually revert back to non-resistant cells in non-selective in vitro conditions.
Since a majority of relatively sensitive cells are preferentially eliminated first by most therapies, lengthy therapeutic evaluations in cell culture provide more useful information about the resistant subpopulation of cancer cells than rapid cell proliferation assays.
6-MP treatment affects cells via mis-incorporation of 6-thioguanine triphosphate into RNA and deoxy-6-thioguanine triphosphate into DNA along with other effects on nucleoside pools and cell signaling. The authors chose low-dose 6-MP for evaluation in our model of adaptable cancer cells because of 6-MP's ability to induce and maintain remission in inflammatory bowel disease and childhood acute lymphoblastic leukemia.
It has also been shown to stabilize quiescence in cancer cells and to sensitize resistant cancer cells to cell death with an apoptosis-inducing agent in a preclinical model of multiple myeloma.

Figure 5: SUM149-MA cells surviving a 6-MP treatment are sensitive to chemotherapeutic drugs. After a 32 days treatment with 2 μM 6-MP, surviving cells were allowed to recover in a drug-free medium for 33 days. Following this, cells were treated in parallel with 5 nM paclitaxel or 50 nM doxorubicin for 6 days and then allowed to recover and grow into colonies for 17 days before staining with crystal violet. Cells treated with DMSO solvent in parallel served as controls. DMSO treated control plates were stained after 6 days. The number of colonies, counted manually on full-size images, are shown on the top right of photographs of dishes. Representative cell cultures are shown.
The Lucci/Balraj Research Team concluded in their Oncotarget Research Output that finally, because immune checkpoint blockade therapy is likely to become common in both neoadjuvant and adjuvant settings in a heterogeneous cancer such as TNBC, the industry must consider any new therapy in this new context.
A common hurdle with the immune checkpoint therapy is severe autoimmune reaction toxicities.
When such therapies are given in the setting of metastasis, they may be combined with other therapies such as cytotoxic agents, which may also adversely affect immunity.
Although therapies like TNF antibodies are useful in managing the acute phase of IBD, 6-MP has been a mainstay for several decades for keeping the disease in remission.
Applying the lessons from IBD treatment to the setting cancer treatment, low-dose 6-MP followed by immune checkpoint blockade could be a good way of limiting severe autoimmune toxicities, thereby increasing the chances of success with these promising therapies.
Sign up for free Altmetric alerts about this article
DOI - https://doi.org/10.18632/oncotarget.27922
Full text - https://www.oncotarget.com/article/27922/text/
Correspondence to - Anthony Lucci - [email protected] and Balraj Singh - [email protected]
Keywords - esistant TNBC, minimal residual disease, intratumor heterogeneity, breast cancer relapse, metastasis prevention
About Oncotarget
Oncotarget is a bi-weekly, peer-reviewed, open access biomedical journal covering research on all aspects of oncology.
To learn more about Oncotarget, please visit https://www.oncotarget.com or connect with:
SoundCloud - https://soundcloud.com/oncotarget
Facebook - https://www.facebook.com/Oncotarget/
Twitter - https://twitter.com/oncotarget
LinkedIn - https://www.linkedin.com/company/oncotarget
Pinterest - https://www.pinterest.com/oncotarget/
Reddit - https://www.reddit.com/user/Oncotarget/
Oncotarget is published by Impact Journals, LLC please visit https://www.ImpactJournals.com or connect with @ImpactJrnls
Media Contact
[email protected]
18009220957x105